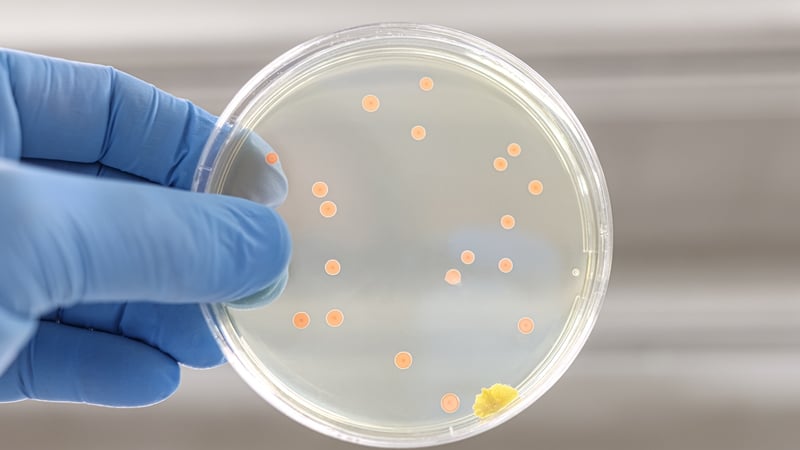
'Sepsis is most commonly caused by infections in the lungs, urinary tract or gastro-intestinal tract'. Photo: Getty Images

Analysis: Sepsis infections and antibiotic resistance continue to have a significant impact on people, families and our health system
Last year Gillian picked up what she thought was a simple chest infection and was prescribed a course of antibiotics. She has a long-term medical condition and is prescribed a medication that has the side effect of suppressing her immune system. This means she is at increased risk of getting an infection.
When the antibiotics prescribed were not able to treat the bugs causing her infection, Gillian spent weeks in hospital acutely unwell with pneumonia. This was followed by several months of long-term treatment, fatigue and she needed to take an extended time off work. Gillian slowly recovered but is vigilant and more cautious of the risk of infection now. "It’s had a big impact really, a huge impact. Psychologically, physically, my work, my identity…it has really affected so much."
We need your consent to load this rte-player contentWe use rte-player to manage extra content that can set cookies on your device and collect data about your activity. Please review their details and accept them to load the content.Manage Preferences
From RTÉ Radio 1's Today with Claire Byrne, what are the risks and symptoms of sepsis?
Gillian was one of the many people who shared their story in new research conducted by UCC researchers and published by the Department of Health this month. In this report, patients, family members and healthcare staff shared their stories of the impact of sepsis, infection and antibiotic resistance.
The stories highlight the emotional toll as well as physical impact of their experience and the worry and lack of understanding of what was going to happen. They portray the psychological and physical impact of long hospital stays with multiple courses of antibiotics given in an effort to treat complicated infections, with some patients isolated in single rooms for long periods of time, and many experiencing feelings of loneliness, fear, depression and anger.
How do you catch sepsis?
The truth is that you don’t catch sepsis. Any infection in any part of the body can lead to sepsis. Not all infections lead to sepsis, but in some cases the immune system becomes overactive and starts to damage the body’s own tissues and organs. Sepsis is most commonly caused by infections in the lungs, urinary tract or gastro-intestinal tract. With most cases starting in the community, everyone must remember the signs of sepsis and seek medical attention if these arise.
We need your consent to load this rte-player contentWe use rte-player to manage extra content that can set cookies on your device and collect data about your activity. Please review their details and accept them to load the content.Manage Preferences
From RTÉ Radio 1's Liveline, listeners call in to talk about their experience of sepsis
Some people are at higher risk of sepsis; infants, older adults, those with frailty of multiple health conditions, people living with chronic diseases such as diabetes, kidney disease, respiratory disease, people that have recently had surgery or a serious injury, people with an invasive medical device such as a urinary catheter. More and more people are prescribed long-term medications which can suppress their immune system and increase the risk of infection.
How are sepsis and antibiotic resistance connected?
Antibiotic resistance occurs when bugs or germs that cause infection no longer respond to the usual antibiotic treatment. Antibiotic resistance complicates the treatment of sepsis, reducing our treatment options as antibiotics become less effective. Antibiotic resistance is a current global threat, with both the World Health Organisation and United Nations calling for action to address this silent pandemic. Antibiotics are a precious resource in healthcare and society, and with the majority of antibiotics being prescribed in primary care, we must work collectively to ensure we use them carefully.
The long-term impact of sepsis and infections
In our report, people spoke of the significant long-term consequences that sepsis and infections can have on their physical, psychological and emotional health. Post sepsis syndrome is a recognized consequence of sepsis for some people and can result in reduced physical health, such as fatigue, muscle and joint pain, shortness of breath and cognitive side effects such as reduced concentration and memory impairment.
We need your consent to load this rte-player contentWe use rte-player to manage extra content that can set cookies on your device and collect data about your activity. Please review their details and accept them to load the content.Manage Preferences
From RTÉ Radio 1's Morning Ireland, calls on Government to introduce mandatory sepsis protocols in all hospitals
Support for people and families who lose a loved one from sepsis, or who survive sepsis, is needed as part of the rehabilitation journey. Significant strides have been made in cancer survivorship programmes and cardiac rehabilitation services which aim to prevent further events and improve quality of life. The Global Sepsis Alliance 2030 Global Agenda for Sepsis calls for increased investment and development of support for the short term and long term sepsis journey.
Patients in our report recognised the important support they received from patient advocacy groups such as the Irish Sepsis Foundation. As well as supporting those through the acute and long-term period of sepsis, advocacy groups improve the narrative around sepsis to raise public awareness and connect people, families, healthcare staff and policy stakeholders.
What can we do to reduce the impact of sepsis?
The advice we give to reduce the risk of infection will reduce the risk of sepsis. Ensure your vaccinations are up to date, especially for babies, children, pregnant women and people over 65-years-old. Practice good hand hygiene, protect yourself by cleaning any cuts or wounds and cover your coughs and sneezes. Take your prescribed antibiotics as instructed and follow the instructions.
We need your consent to load this rte-player contentWe use rte-player to manage extra content that can set cookies on your device and collect data about your activity. Please review their details and accept them to load the content.Manage Preferences
From RTÉ Radio 1's Morning Ireland, around 3,000 people die every year of sepsis in Ireland
As well as the measures to reduce the risk of infection, the stories from people, family members and healthcare staff have highlighted the need for clear and accessible information on sepsis, infections and antimicrobial resistance to address gaps in public understanding. In higher education, we need to educate and train our healthcare professionals to take the time to explain these complex terms to people and their families.
Improving health literacy in these areas will improve understanding, help people to recognize the signs of sepsis, and encourage early presentation for medical help. People who shared their story spoke of the importance of healthcare professionals taking the time to explain, to support their understanding and involvement in the decisions about their care.
The stories shared in the report, and others, highlight the human and societal cost of sepsis and infections. The report was conducted to meet an objective of the second Irish National Action Plan (2021-2025) on Antimicrobial Resistance. The people who contributed to this report have done so to raise awareness, help others and save lives. In Paul’s words, "I had the experience and the whole idea is to share so that other people might benefit."
September is Sepsis awareness month. Further information on the signs of sepsis is available here.
The author would like to acknowledge the work of her co-authors Dr Clara Heinrich, Dr Teresa Barbosa, Dr Maura Smiddy, Dr Michelle O’Driscoll, Dr Kevin Murphy and Ms Sandra Murphy, for research undertaken for this project. The significant contribution of all people, family members and healthcare staff who contributed to the report is acknowledged.
Follow RTÉ Brainstorm on WhatsApp and Instagram for more stories and updates
The views expressed here are those of the author and do not represent or reflect the views of RTÉ